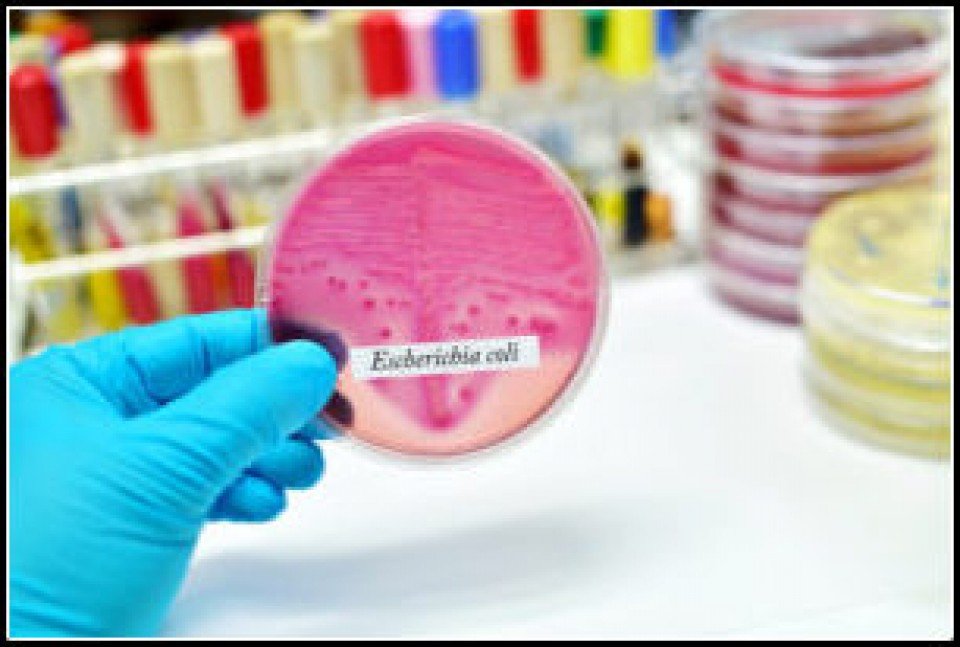

Situación de la robótica móvil en la Argentina...
- Trivia Concurso ¿Qué sabes de Juárez?
- Concurso: ¿Qué sabes de Juárez?
- Incidencia de los animales transgénicos
- Día del Escudo Nacional
- Reglamento de la pesca deportiva en Bs. As.
- Extinción del pez remo gigante
- CAME y su propia fintech
- La ideología bloquea la inteligencia
- Día de la Antàrtida
- El lenguaje inclusivo
Notas
Dinero electrónico y nuevo CBU 0

Los cheques y el efectivo, en retroceso. Por comodidad, agilidad y seguridad ya se realizan 6 millones de operaciones por mes....
Pìldoras con embalaje de bacterias 0
El concepto de microbiomas ha permitido revolucionar las nuevas estrategias ...
Test del emprendedor 0

Mucho hemos hablado sobre los emprendedores. Este test te ayuda a recordar las cosas que se necesitan tener ´para lograrlo. Para entretenerse y aprender.
Cuando lo improbable se vuelve posible 0
El hombre en el espacio. Este video te muestra a un mèdico argentino trabajando con los astronautas...
Apósito antimicrobiano inteligente 0
La Dra. María Emilia Villanueva desarrolló un material que ayuda a la cicatrización de heridas....
¿Cómo se produce el olor a tierra mojada? 0

La responsable del olor a tierra mojada es una sustancia química...
Cómo se hacen los lapices 0
Materiales y procedimientos en la fabricacion de lapices de grafico.
Especies exóticas invasoras 0

En la última década la actividad humana acelerò el movimiento de especies a tasa alarmantes. Este fenòmeno empobrece la diversidad biològica ....
Tener una marca propia 0

Hasta ahora las marcas propias eran exclusividad de los grandes distribuidores y las grandes cadenas que podían permitirse manufacturar y distribuir productos creados para sus necesidades y las de su público....nota completa
Guía Comercial
Guía Telefónica
Ingrese parte del nombre o del apellido de la persona que esta buscando.
Patricia A Gomez
Quiero jugar...
Ver notaCarlos Ferreyra
Hace un año tuve la felicidad de conocer este emp...
Ver notaBianca victoria sposino
Hola ami me gustan los caballos y mi papá tienen ...
Ver nota